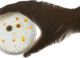
Genetically engineered bacteria make living materials for self-repairing walls and cleaning up pollution

Genetically engineered bacteria make living materials for self-repairing walls and cleaning up pollution
As a material, bacteria’s ability to rapidly multiply and adapt to different conditions is an asset. Gschmeissner/Science Photo…
October 27, 2022